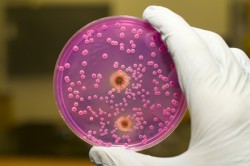
Лабораторная диагностика Лабораторная диагностика

Одно из самых опасных и коварных заболеваний — простатит. Опасен он отнюдь не своими неприятными симптомами, а последствиями. Простатиту подвержены представители сильной половины человечества.
Для того чтобы лечение было как можно более эффективным, обязательно нужна точная диагностика простатита, которая поможет выявить заболевание даже на ранних стадиях.
На сегодняшний день причины, по которым возникает данное заболевание, до конца не определены. Но специалисты называют несколько факторов, которые могут спровоцировать появление простатита. К ним относят:
- сильные стрессы;
- малоподвижный образ жизни;
- отсутствие регулярного секса;
- неблагоприятная экологическая обстановка и так далее.
Каждый мужчина, который неравнодушен к своему здоровью, должен позаботиться о профилактических мероприятиях, чтобы избежать серьезных проблем в будущем. Практика показывает, что заболеванием простаты страдает чуть ли не каждый второй мужчина. Во многих случаях простатит переходит в хроническую форму, что заметно усложняет лечение.
Несколько способов диагностики простатита
В основе диагностики лежит ректальное пальцевое исследование предстательной железы. Кроме того, необходимо сдать некоторые анализы, без которых не обходится ни одна диагностика простатита. Основная картина вырисовывается исходя из жалоб пациента и данных лабораторных исследований.
Врачи подчеркивают, что диагностика простатита требует комплексного подхода. Основные симптомы, такие как боль в области таза, затрудненное мочеиспускание и дискомфорт в области половых органов, могут варьироваться в зависимости от формы заболевания. Хронический простатит часто проявляется менее выраженными симптомами, что затрудняет его своевременное выявление. Специалисты рекомендуют проводить регулярные обследования, особенно мужчинам старше 40 лет, чтобы исключить не только простатит, но и другие заболевания предстательной железы. Лабораторные анализы, включая анализ мочи и секрета простаты, а также ультразвуковое исследование, играют ключевую роль в установлении точного диагноза. Врачи акцентируют внимание на важности раннего обращения за медицинской помощью, так как это может значительно улучшить качество жизни пациента и предотвратить развитие осложнений.

Основные признаки простатита

- болевые ощущения или дискомфорт внизу живота, в яичках, прямой кишке, половом члене, прямой кишке или в пояснице;
- болезненный процесс или частое мочеиспускание, ощущение того, что мочевой пузырь опорожнен не полностью;
- сексуальная дисфункция.
Симптомы простатита беспокоят не постоянно, а периодически, при этом они могут то усиливаться, то ослабевать.
Виды простатита
Острый простатит обуславливается воспалением предстательной железы, которое вызвано инфекцией. Для данной формы характерен относительно небольшой срок заболевания — менее трех месяцев.
Основными признаками острого простатита являются:
прострелы в промежности, при этом боль может отдавать в другую область нижней части живота;
- боли и другие проблемы, связанные с мочеиспусканием. Также при острой степени простатита может создаваться ощущение постоянного позыва на мочеиспускание.
Кроме этих проблем, могут возникнуть и другие признаки: лихорадка, озноб, повыситься потоотделение и так далее.
При остром простатите могут возникнуть нежелательные осложнения: абсцесс предстательной железы, сепсис, парапроктит. При отсутствии качественного лечения он может перейти в хроническую форму.
Хронический простатит. Воспаление может возникнуть и без участия инфекций. Опасность данной формы заключается в том, что не у всех больных есть шанс на выздоровление. Самый основной симптом в этом случае — болевые ощущения в любой области таза, но чаще всего в промежности. Во время ходьбы боль может ослабнуть, а в сидячем положении она обычно усиливается.
Многие принимают за признаки простатита боли в одном из яичек, но, скорее всего, это может быть признак другого заболевания.
Хронический простатит может сопровождаться болью после эякуляции. Наличие этого признака позволяет отбросить вероятность того, что в предстательной железе образовалась доброкачественная гиперплазия.
Многие мужчины, столкнувшиеся с проблемами простатита, отмечают, что симптомы этого заболевания могут быть весьма разнообразными и порой неожиданными. Часто пациенты жалуются на боли в области таза, дискомфорт при мочеиспускании и даже сексуальные расстройства. Некоторые отмечают, что симптомы могут проявляться в виде частых позывов в туалет, особенно ночью, что значительно ухудшает качество жизни.
Мнения о диагностике простатита также различаются. Некоторые мужчины считают, что процесс обследования может быть неудобным и стеснительным, однако многие врачи подчеркивают важность ранней диагностики для успешного лечения. Пациенты часто делятся опытом, что своевременное обращение к специалисту и выполнение всех необходимых анализов помогли им избежать серьезных осложнений. В целом, открытое обсуждение симптомов и диагностики простатита становится все более актуальным, что способствует повышению осведомленности и снижению стигмы вокруг этого заболевания.
https://youtube.com/watch?v=d9rtc1GOSyc
Основные виды диагностики
Виды диагностических исследований:
Пальцевое исследование
Осуществляется через прямую кишку. Это исследование предстательной железы является обязательным, поэтому не стоит им пренебрегать. Пальцевая диагностика простатита проводится следующим образом:
объяснение пациенту сути исследования;
- пациент принимает коленно-локтевое положение, которое считается самым удобным для получения качественного результата;
- специалист, надев перчатки и смазав палец специальным гелем, вводит палец в задний проход. Стоит отметить, что ощущение не из приятных, особенно если на прямой кишке имеются трещины или геморроидальные узлы;
- далее нужно найти уплотнение, которое расположено на передней стенке кишечника в нескольких сантиметрах от заднего прохода — это и есть предстательная железа;
- задача специалиста оценить состояние поверхности, величину, консистенцию, а также насколько чувствительна предстательная железа.
В нормальном состоянии железа должна быть примерно 3 см., иметь гладкую поверхность и плотную консистенцию. Она должна хорошо прощупываться, при этом не вызывая болевых ощущений. На ощупь должны четко различаться две доли, между которыми имеется небольшая борозда.
Если у пациента рак, то предстательная железа будет увеличена. Ее поверхность при данном заболевании неровная и твердая на ощупь, напоминает каменистую консистенцию.
Железа также увеличена и при аденоме простаты, поверхность будет более гладкой, а консистенция тугая и эластичная, напоминает резину, из которой обычно делают ручные эспандеры.
Хронический простатит характеризуется наличием отеков и болезненных ощущений. Если надавить на железу, боль будет отдаваться в половом члене. Структура поверхность в данном случае будет напоминать резиновый мячик, которым обычно играют дети.
После проведения пальцевого исследования из заднего прохода могут появиться гнойные выделения, это говорит о явном наличии простатита.
Лабораторное исследование
- подсчет количества лейкоцитов, которые находятся в секрете предстательной железы;
- подсчет количества лейкоцитов в моче. При этом необходима только первая порция мочи;
- подсчет количества лейкоцитов в моче и ее бактериологическое исследование после того, как была проведена процедура массажа железы;
- подсчет уровня простатического антигена, который может повыситься во время заболевания простатитом.
Инструментальное исследование
Зачастую, чтобы получить полную информацию о состоянии предстательной железы, визуальных методов недостаточно.
Поэтому для более полной диагностики простатита необходимо:
- выявить камни или абсцессы, которые могут быть причиной воспаления предстательной железы. Это можно сделать при помощи трансректального УЗИ или компьютерной томографии таза;
- при наличии инвазивных манипуляций органов мочеполовой системы может быть назначена цистоскопия.

Чтобы в кратчайшие сроки вылечиться от одолевшего недуга, очень важно сделать грамотную диагностику. На основании полученных данных врачи поставят правильный диагноз и подберут необходимый вариант лечения. Только точная диагностика и своевременно начатое лечение этого недуга приводят к полному восстановлению нормальных функций предстательной железы.
Вопрос-ответ
Как проверить, есть ли простатит или нет?
Острый простатит проявляется общей интоксикацией с появлением лихорадочного синдрома, повышенной температуры тела. Появляются выраженные симптомы простатита: боли в паху, прямой кишке и промежности. Мужчина отмечает частые позывы и болевой синдром после мочеиспускания.
Как проверить простату самому себе?
Необходимо лечь, развести ноги, смазать вазелином или детским кремом указательный палец и ввести его в задний проход. Бугорок предстательной железы определяется по передней стенке прямой кишки, на несколько сантиметров выше ануса.
Как уролог определяет простатит?
Диагностику болезни начинают с врачебного осмотра. Уролог выполняет пальцевое исследование простаты, в ходе которого он оценивает консистенцию органа, а также выявляет увеличение его размеров. Врач изучает жалобы больного и выясняет, как протекало заболевание.
Каковы симптомы простаты у мужчин?
Простата — это орган у мужчин, который окружает уретру, выводящую мочу из организма. Болезни простаты, такие как увеличение простаты или рак, могут препятствовать нормальному потоку мочи, затрудняя мочеиспускание и вызывая боль. Лечение заболеваний простаты может варьироваться в зависимости от типа и тяжести болезни.
Советы
СОВЕТ №1
Регулярно проходите медицинские обследования. Простатит может развиваться бессимптомно, поэтому важно посещать врача для профилактических осмотров, особенно если вам за 40 лет.
СОВЕТ №2
Обратите внимание на симптомы. Если вы заметили частые позывы к мочеиспусканию, боль в области таза или дискомфорт при мочеиспускании, не откладывайте визит к врачу.
СОВЕТ №3
Поддерживайте здоровый образ жизни. Правильное питание, регулярные физические нагрузки и отказ от вредных привычек могут помочь снизить риск развития простатита и улучшить общее состояние здоровья.
СОВЕТ №4
Не занимайтесь самолечением. Если у вас есть подозрения на простатит, обратитесь к специалисту для получения точного диагноза и назначения адекватного лечения, вместо того чтобы полагаться на народные средства или советы из интернета.

прострелы в промежности, при этом боль может отдавать в другую область нижней части живота;
объяснение пациенту сути исследования;